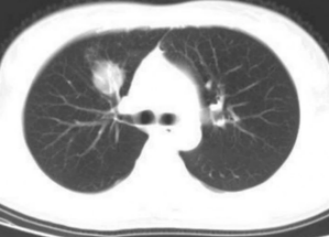

公司邮箱
contact@innermed.com
精湛医术 | 呼吸疾病“照妖镜”!陕中二附院成功开展径向超声支气管镜肺活检术
陕西中医药大学第二附属医院呼吸与危重症医学科曾接诊一位患者。 该患者5个月前在当地医院被诊断为左下肺肺炎,经抗感染治疗后症状好转出院。
但,此后咳嗽、咳痰症状持续存在,虽服用多种抗感染药物,缓解效果均不佳。患者遂至该院呼吸科门诊就诊,经胸部CT检查提示左下肺阻塞性肺炎,随即入住呼吸与危重症医学科。

入院后,科室根据患者胸部CT表现,初步评估病灶位于左肺下叶内基底段某个亚支。该部位依靠常规的支气管镜检查难以触及,为进一步确定病灶位置,结合患者薄层CT,手绘病灶所在支气管各亚段及亚段导航图,利用径向超声小探头进行检查,终于发现了准确的病灶位置。


确定病灶位置后,医生立即对活检组织进行涂片、染色,并快速现场评估。电镜下提示肿瘤细胞,再次印证了活检位置准确无误。

气道内径向超声
英美达呼吸小探头仅有1.0mm,可深入直径2mm左右的细支气管进行检查,主要用于常规支气管镜不能达到的肺外周病变诊断。
当患者胸部CT显示远离中央气道、靠近大血管的肺外周病变时,传统经胸壁穿刺出血风险高,而常规支气管镜又无法到达病灶位置。此时,“小超”凭借其超细、可弯曲的独特设计,能轻松通过支气管镜工作通道,深入远端细支气管,在其精准引导下进行经支气管镜肺活检,大幅提高了肺外周病变的诊断成功率。

呼吸“小超”操作简便,损伤小,安全性高,费用低,并发症少,许多原本需通过外科手术或肺穿刺活检才能确诊的患者,现只需要通过气道内径向超声检查就可以确诊,极大减轻了病人的痛苦,同时也避免了手术操作所带来的风险。